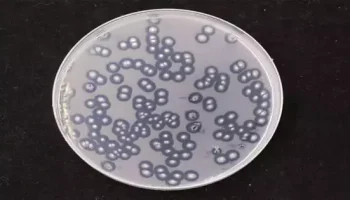

New experiments using ultra-cold atoms in one dimension show that quantum systems with many particles change over time when a lot of energy is added,
Simulated intelligence devices in view of fake brain organizations (ANNs) are being presented in a developing number of settings, assisting people with handling numerous issues quicker and more proficiently. Electronic
Because of its excellent power-conversion efficiency and low price, perovskite solar cells (PVSCs) are a possible replacement for conventional silicon-based solar cells. Nevertheless, ensuring long-term stability has been one of
The hypothesis of relativity functions admirably when you need to make sense of infinite-scale peculiarities —for example, the gravitational waves made when dark openings impact. Particle-scale phenomena like the behavior
Ferromagnets are materials that become charged and remain so while they are presented to an external magnetic field. In these materials, electric flows ordinarily prompt a purported cross-corridor voltage (i.e.,